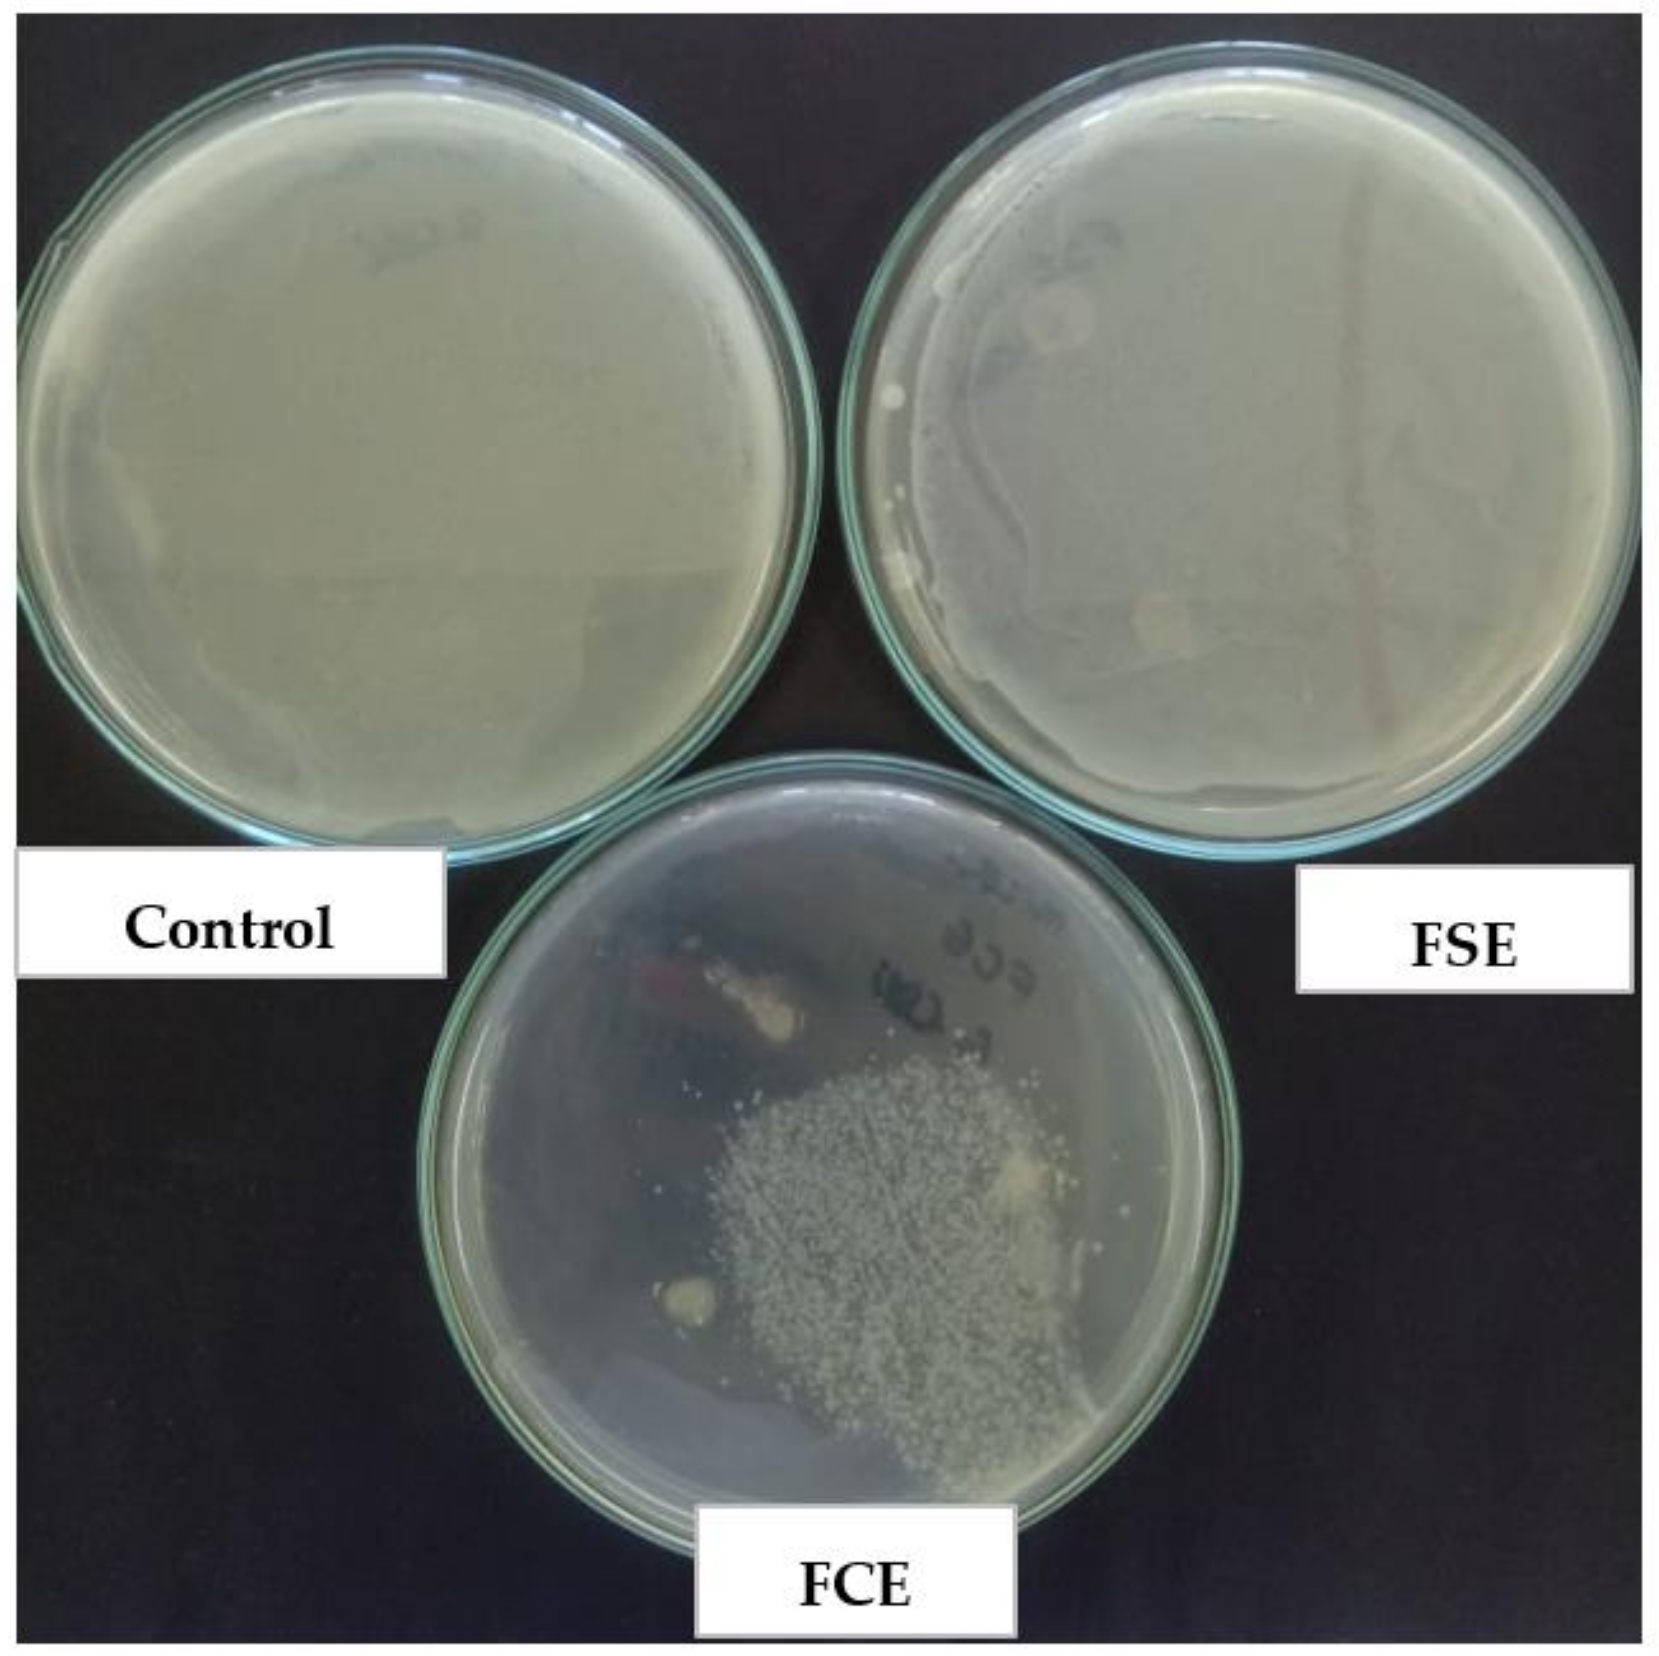
Ijms 22 10628 g006 550

3.1. Optimization of Bioplastic Formulation
The results obtained in the study of the formulation of bioplastic films through experimental design are presented in
Table 2.
From the results, we can see the great variability of responses between treatments, indicating the influence of independent variables on the evaluated responses. The central point (treatment 15, 16, and 17) presented a small variation, showing the reproducibility of the process of obtaining the films. The values obtained for TS and EB varied between 1.31 to 11.15 MPa and 14.90 to 51.03%, respectively, and are in accordance with the ranges found by Andonegi et al. [
25], who studied chitosan–collagen blends with values around 11.03 MPa and 19.7% and Moradi et al. [
26], who obtained rupture tension values between 8.73 to 14.11 MPa when evaluating chitosan–polyethylene films. Jridi, Abdelhedi, Zouari, Fakhfakh, and Nasri [
27] also obtained similar values for elongation at rupture when studying the interaction of compounds such as Arabic agar and gelatin-agar, where the values varied from 7.59 to 27.25%.
Figure 1 indicates that for the tensile strength response the effect of the glycerol, agar-agar, and chitosan variables was significant, indicating that with the increase of plasticizer the resistance is decreased. The same was observed by Chevalier, Assezat, Prochazka, and Oulahal [
28] in which films with 13.2% glycerol had TS between 16 and 38 MPa and films with a higher amount of plasticizer (24.2% glycerol) had TS between 2 and 13 MPa, which is due to the interaction between water and glycerol molecules, which leads to decreased intermolecular interactions, increasing the formation of vacant spaces and consequently decreased mechanical resistance [
29]. The higher the agar-agar proportion, the greater the tensile strength, due to the increase of the hydrogen bonds between the molecules, producing a more compact structure [
30,
31].
For the elongation at rupture, the negative effect of the agar-agar variable was significant, indicating that when the agar-agar concentration increases, the elongation is reduced. Wu, Geng, Chang, Yu, and Ma [
31], when studying the effect of agar concentration in potato starch films, observed that the addition of agar-agar up to 5% in relation to the amount of starch contributed to the increase in elongation, with higher concentrations of agar observed with a decrease in elongation capacity. With lower concentrations, the agar allows the absorption of moisture, which decreases the hydrogen bonds, increasing the mobility of the film and increasing the elongation. However, at higher concentrations, agar acts in the formation of bonds between hydrogen and the polymer, restricting the mobility of the polysaccharide chains and consequently an increase in elongation.
The analysis of variance (ANOVA) with a 90% significance level per residual SS was performed and the results are shown in
Table 3.
It was possible to confirm the fit of the mathematical statistical models to the data obtained and their significance (R
2 > 0.8 and Fcal > Ftab) (Equations (9) and (10)). The squares express the coded values of the model
where
(A) is agar-agar, (
C) chitosan, and (
G) glycerol.
The optimization of experimental conditions to obtain films with better responses, TS, and EB was performed through the desirability analysis (
Figure 2).
According to the profile analysis, a desirability of 0.99 between a scale of 0 to 1 was obtained. The optimization considering the real variables was: 0.50 g, 0.49 g, and 0.15 g for agar-agar, chitosan, and glycerol, respectively, indicating the obtaining of films with 10.48 MPa of TS and 20.31% of EB. After playing the movie in the conditions indicated by the optimization and characterization, the responses found were 13.57 ± 2.17 MPa and 15.51 ± 2.87%, respectively. Both results can be considered similar to those predicted in the model, resulting in a bioplastic with the best characteristics according to the studied variables. The values found indicate good characteristics, being suitable in handling the packaging, allowing it not to break when wrapping the food, and to remain intact during transport, packaging, and handling.
3.2. Characterization of Active Bioplastic Film
The results of the mechanical properties are illustrated in
Table 4.
TS and EB did not present a significant difference (
p < 0.05) for films with and without the extract, which indicates that the extract did not interfere significantly in the mechanical resistance of the film. According to Pastor, Sánchez-González, Chiralt, Cháfer, and González-Martinéz [
32], this property depends on the composition of the film, especially the concentration of polymers, which was not changed for the synthesis of ESF and FCE, which explains this behavior. This result indicates that there was possibly the interaction of all constituents used in the synthesis of bioplastics. Sánchez-González, Cháfer, González-Martínez, Chiralt, and Desobry [
33] attributed that to the addition of active compounds being able to provide structural discontinuities in the material due to the immiscibility of the constituents, leading to a decrease in intramolecular forces and consequently a reduction in mechanical properties. The results differed from [
15,
34,
35], who reported a reduction in mechanical properties of films added of other compounds (extracts) in relation to the control film.
The TS results of the FCE and FSE films were slightly higher than those of [
36] of incorporated chitosan with 1.5% grapefruit seed extract, which showed a tensile strength of 8.93 MPa. For the EB response, the films showed lower results than the green tea extract embedded agar–gelatin films prepared by Giménez, Lacey, Santín, López-Caballero, and Montero [
37], where they obtained 59% elongation, however, the handling of both was satisfactory.
Table 5 presents the results of the physical, barrier, and chemical characterization for films produced with and without extract.
The thickness of the films showed a significant difference between the FCE and FSE control film due to the addition of solids present in the extract. Riaz et al. [
17] explained that thickness could also be changed due to the molecular interaction of polymers with the extract, and there may be short distance bonds, resulting in a more compact structure and consequently greater thickness. Similar findings were described by Kanmani and Rhim [
38] in agar-based films incorporated with grapefruit seed extract, which obtained films in the range of 0.036 to 0.053 mm and Kaya et al. [
39] in the range of 0.045 to 0.099 mm in chitosan films with fruit extract and
Berberis crataegina seed oil.
The water vapor permeability (
Table 5) did not present significant difference between the FCE and FSE films. Both materials presented lower values than those reported by [
40,
41] on agar-agar films reinforced with nanocrystalline and nanobacterial pulp, respectively, Hankar and Rhim [
42] on agar-agar and Reddy composite films; and Rhim [
43] on agar and blackberry pulp nanocellulose films, which is a promising result. When water vapor permeability is favored in food products, they generally have a shorter lifespan due to the transfer between the external environment and the product, thus the use of bioplastic films aims at reducing this transfer.
The results for water solubility indicate a significant difference between films with and without the extract. The film with the extract had twice the solubility, possibly due to its hydrophilic characteristics, similar to what occurred with Narasagoudr, Hegde, Chougale, Masti, and Dixit [
44] in chitosan and poly(vinyl alcohol) films. However, the values were lower when compared to [
45,
46] in gelatin and chitosan films and Wang and Rhim [
47] in agar-agar, alginate, and collagen films, which presented films with solubility around 43.45%, 58.13%, and 63%, respectively. This is due to the presence of chitosan in the formulation, which has hydrophobic behavior. The solubility of the bioplastic film is important when an application in food is intended, especially when the food presents high content of humidity, which is the desired application in this study.
The property of swelling is the capacity of the film to retain water and the lower this capacity, the more effective the barrier of the food with the external environment. The values obtained indicate that there has been a significant decrease in the swelling property of the film containing the bacteriocin extract in relation to the control film. The values found in this study were below those found by Wang and Rhim [
47] and [
16] in agar-agar films with 2363.7% and gelatin with 400%, respectively, and similar to those found by Riaz et al. [
17] in chitosan films with Chinese chives root extract, where they also observed a reduction in the degree of swelling with the addition of the extract from 57.38% to 40.49%, explained by the presence of hydroxyl (hydrophilic groups) in the chitosan molecule.
The visual characteristics of a package are attractive to the eyes of the consumer, which are often influenced by the color and transparency of the materials used [
17]. The values of color, transmittance, and opacity of the bioplastic films developed are presented in
Table 6.
The control film was transparent and the addition of the extract decreased the transparency and consequently increased the opacity, with a slightly yellowish color (
Figure 3). The total color difference indicates greater color in the film with the extract. The decrease of transmittance is a good characteristic when one intends an application as a barrier in the food area, since it protects the food from oxidation, loss of nutrients, and discoloration [
48]. These observations are according to Rubilar, Candia, Cobos, Díaz, and Pedreschi [
49] in films of chitosan with nanoclay and LAE (ethyl Nα-dodecanoil-
l-arginate), found a decrease in transmittance in relation to the control film, and differed from Haghighi et al. [
50] in films of chitosan and polyvinyl alcohol, which obtained only transparent films, regardless of the presence or not of the extract, because all showed opacity below 5. Adilah, Jamilah, Noranizan, and Hanani [
51] in fish gelatin films incorporated of mango shell extract also observed an increase in the opacity of the films as the extract was added, however, they reported opacity values below those found in this study, ranging from 0.06 to 1.11 A·mm
−1.
The FTIR spectra of the film with and without extract as well as the biopolymers (agar-agar and chitosan) were performed to determine the interactions of polymers and extract, and are shown in
Figure 4.
Peaks in the range 3210–3305 cm
−1 indicate the presence of hydroxyl (OH), however, a certain displacement between the samples is noticeable, indicating that there was an interaction of its constituents, caused by a small absorption displacement [
52]. The peaks between 2900–2980 cm
−1 were verified in all samples and refers to grouping CH [
53]. The peaks around 1074 cm
−1 present in all samples were due to the CO group [
43], where again, the interaction of the compounds was noticed because the biopolymers presented lower peaks in this same wavelength, and the films without and with the extract presented more intense peaks, being more pronounced in the FCE, demonstrating the interaction of this grouping. The peak 1558 cm
−1 expressed in FCE and chitosan corresponded to the NH connection [
54]; the other samples presented a peak very close to this, probably referring to the vibration of the ester grouping (COO
−) around the band of 1562 cm
−1 [
55]. The 1437 cm
−1 peak present in all samples and of different intensities corresponded to the shear vibration of the CH grouping [
56,
57].
The surface area, volume, and pore size for the bioplastics samples with and without the extract were estimated by the BJH method (Barret, Joyner, and Halenda) and can be seen in
Table 7.
The film with the extract showed a small reduction in surface area and pore size due to the interaction of biopolymers with the extract. Zhong, Zhuang, Gu, and Zhao [
58] observed that when there was an increase in the molecular weight of the solution, in this case caused by the addition of the extract, the film tended to become more compact and consequently less porous, however, both samples were presented as microporous. According to Teixeira, Coutinho, and Gomes [
59], sizes equal to or less than 200 Å are thus classified. Saibuatong and Phisalaphong [
18] also obtained microporous films with a surface area of 15.7 m
2g
−1, synthesized from bacterial cellulose with the addition of 30% aloe vera.
The results of the thermogravimetric analysis can be seen in
Figure 5, where it can be seen that both films presented three main stages of degradation, with the first stage of degradation between 40 and 45 °C attributed to water evaporation, and weight loss around 10% [
60]. The second stage of degradation for the FCE at a temperature of 231.9 °C corresponded to the degradation of cellulose material (agar-agar) [
61]; the FSE presented a peak at 169 °C, which refers to the degradation of plasticizer (glycerol) [
62], possibly the bacteriocin extract collaborated for a greater interaction of the plasticizer with the polymeric matrix, contributing to its greater thermal stability. The third stage refers to the degradation of chitosan, in a range of 252–294 °C [
63]. It was also noted that the results for the control film were similar compared to the added bacteriocin extract film, corroborating the results of the mechanical properties, surface analysis, water vapor permeability, and FTIR.
When the bioplastic film has an application for a food product, it is interesting that it does not break down at the food packaging temperatures, since the degradation of the polymeric film indicates the end of the food protection, once the film is undone. In this sense, the developed film presented good thermal characteristics, being degraded at high temperatures.
Qiao, Ma, and Liu [
64] reported degradation of glycerol in chitosan films at 110 to 120 °C, and in chitosan films with a fungal extract around 140 to 210°C. The same authors observed degradation of chitosan at 266 °C for the chitosan control films and 257 °C for the chitosan films plus fungal extract.
Hankar and Rhim [
42] observed a thermal degradation around 300 to 370 °C in agar composite films associated with agar degradation, since cellulosic materials have a degradation temperature in this neighborhood. Reddy and Rhim [
65] reported a wider range of thermal degradation for cellulosic materials, from 200 to 370 °C, obtained on agar films and nanocellulose with papier-mâché pulp, a temperature range that was associated with agar degradation.
3.2.1. In Vitro Antibacterial Analysis
The antibacterial effect of the purified bacteriocin extract and the embedded film extract can be seen in
Table 8. In the film without extract, only with the presence of biopolymers (chitosan and agar-agar) and glycerol did it show no inhibition zone before the tested microbiota, which is in accordance with [
66,
67,
68], who explained that chitosan when in film form presents negligible antimicrobial properties, because it does not diffuse in the culture medium. In this way, only the organism in direct contact with its active sites is inhibited, because it is necessary that the amino grouping present in the chitosan, which is positively charged, enters in direct contact with anionic groups present in the surface of the cell of the microorganism, so that they can react and then inhibit the synthesis of new proteins.
The absence of bacterial growth around the films or extract is characterized by a clear zone, visible to the naked eye, and called a halo of inhibition. When the microorganisms
Escherichia coli and
Salmonella enteritidis were analyzed, there was no significant difference (
p < 0.05) between the bacteriocin extract and the film incorporated with it. For
Staphylococcus aureus, the film presented a greater halo of inhibition than the extract, indicating that the extract has possibly been potentiated when entering in contact with the chitosan, showing itself more efficient in front of microorganisms with a Gram-positive membrane. The results indicate that the bacteriocin extract has antibacterial action when applied to the bioplastic film, since it maintained or increased the inhibition halos, thus confirming the efficiency of the bioplastic film developed in this study and its potential to be applied as active packaging in a food. Similar findings were reported by Sugumar, Mukherjee, and Chandrasekaran [
69] found inhibition halos of 7, 11, and 15 mm for chitosan films with different concentrations of
eucalyptus oil nano-emulsion against
Staphylococcus aureus. Wu et al. [
70] reported inhibition halos between 6 and 9 mm for
Escherichia coli and 8 to 19 mm for
Staphylococcus aureus in chitosan nanocomposites and Ԑ-polylisin.
With the concern of real efficiency in the application as active packaging, the microatmosphere test (
Figure 6) indicates that the packaging does not need to be in direct contact with the food to be effective, since the active compound has volatility and can act, even if not in direct contact.
Figure 6 indicates the development of
E. coli, inoculated in the Petri dish (control), and two more Petri dishes where the
E. coli culture was sown, with the one called FSE containing the film without the incorporation of the extract and the one containing the film with the incorporation of the bacteriocin extract (FCE). It is noted that in both the control and in the FSE, there was a clouding of the culture medium, indicating the proliferation of
E. coli after 24 h of incubation, while in the FCE, small colonies can be seen in a region of the plaque, suggesting that the volatilization of the compound occurred and was efficient in inhibiting microbial development. With this technique, the inhibitory action is due to the volatile compounds of the extract, which in the vapor phase comes into contact with microorganisms [
71]. The results are in accordance with those of Kashiri et al. [
72], who obtained positive effects for the microatmosphere test for
Listeria monocytogenes and
Escherichia coli in zeine films with the essential oil of
Zataria multiflora Boiss; however, a greater concentration of the extracts used was necessary in comparison with disc diffusion analysis under the same conditions. Dannenberg et al. [
73] obtained satisfactory results in microbial reduction of
Salmonella Typhimurium,
Staphylococcus aureus, and
Listeria monocytogenes when using pink pepper essential oil as an antimicrobial in cellulose acetate film.
Thus, the developed film has potential for application in a food product as it has adequate mechanical characteristics for handling and packaging, has excellent physical and barrier properties as well as antibacterial capacity, and can act both in direct contact and by microatmosphere, thus helping in increasing the product’s lifespan.
3.2.2. Release Profile
The release profile of the bacteriocin extract incorporated in the bioplastic film (aga-agar/chitosan) is illustrated in
Figure 7, where it is noted that bacteriocin was gradually released, reaching the maximum release between the third and fifth day of contact with the simulant solution, where it presented 66.07 ± 1.2% of inhibition against
Escherichia coli on the third day and 78.61 ± 2.3 under
Staphylococcus aureus on the fifth day. The release profile was traced from the activity of the compound and not the compound itself, in this way, as the test microbiota is composed of different microorganisms, one representative of the group of Gram-positive and another of Gram-negative, the performance of the bacteriocin occurred differently due to the divergence of cell walls.
The gradual release is made possible by the characteristics of the polymeric matrix [
74] mainly by solubility and porosity, which was favored in this study, since the film presented a low solubility (20.97%) and a microporous surface analysis (22.45 Å). The release of bacteriocin extract provided microbial inhibition, so the profile was elaborated in front of the inhibition that occurred in front of the microbiota test, where it was noted that during the whole time of analysis, the microbial reproduction was reduced in comparison with the control sample (time 0), which presented 100% microbial growth and in turn 0% of inhibition.
The same analysis was performed with the film without extract (FSE), and showed no signs of inhibition, indicating that the inhibition observed in the FCE came from the bacteriocin extract added to the formulation.
Roy and Rhim [
52] found that in chitosan and curcumin films, curcumin is released in up to 100 min and slows down to the point of balance with the solution. Xu et al. [
23], when analyzing films of gum Arabic and chitosan incorporated with essential oils of cinnamon and clove, found an initial fast release that remained constant during 600 min, in 40 min, there was a release of 58.90% of the oils and 99.42% in 300 min of contact with the same simulant solution analyzed in this study. Chen, Xiao, Cai, and Liu [
22] observed a release of 60% of the tea polyphenol in 150 min of contact with the simulant solution and was kept constant for 600 min, when analyzing zein and gelatin films with polyphenol.
3.3. Microbiological Monitoring In Situ
The results of the microbiological follow-up of the Minas Frescal cream cheese are shown in
Table 9.
It was observed that after storage, a reduction in the count was obtained including the control film, due to injuries caused by the cold, which was predicted because the cold acts in inhibiting or delaying the multiplication of microorganisms [
75]. However, the film with extract (FCE) contributed to a greater reduction in the microbial load, since it showed a 53.4% reduction compared to the FSE in the same storage time. The FCE reduced 2.62 log CFU/g, while the FSE reduced 1.79 log CFU/g.
Seydim, Sarikus-Tutal, and Sogut [
76], in 15 days of storage of Kasar cheeses using whey protein films with nisin as a separator, obtained a log reduction for
Escherichia coli and
Staphylococcus aureus. Artiga-artigas, Acevedo-Fani, and Martín-Belloso [
77] also found a decrease from 6 to 4.6 log CFU/g in the count of
Staphylococcus aureus during 15 days of storage of cheese samples coated with an edible nanoemulsion-based essential oil of oregano and tangerine fiber.
Dannenberg et al. [
73], when analyzing the antibacterial action of cellulose acetate films incorporated with pink pepper essential oil in sliced mozzarella cheese, obtained a reduction from 4.30 to 2.91 log CFU/g for
Staphylococcus aureus in 12 days of storage and found no significant action for
Escherichia coli. Goksen, Fabra, Ekiz, and López-Rubio [
78] found a reduction of 1.7 and 1.6 log CFU/g in the growth of
Staphylococcus aureus by adding zein film with essential oil extracted from
Laurus nobilis (bay leaf) and
Rosmarinus officinalis (rosemary), respectively, in slices of Gouda cheese for a time of 28 days. Youssef, El-Sayed, El-Sayed, Salama, and Dufresne [
79] found a reduction of 1.30 log CFU/g in the coliform group over a period of 30 days in Egyptian soft white cheese when using a bionanocomposite film of chitosan/carboxymethyl cellulose/zinc oxide.
In light of what has been reported, the importance of using this type of active packaging is noted, in order to reduce the incidence of these high contaminations. It can be seen that the bacteriocin embedded film studied in the present work has reduced from 1.1 × 106 ± 1.65 × 105 CFU/g for 3.7 × 103 ± 4.36 × 102 for Staphylococcus aureus and 150 ± 43.3 NPM/g for 23 ± 0.00 NPM/g for Escherichia coli, presenting itself as a great alternative for use in products of this origin.